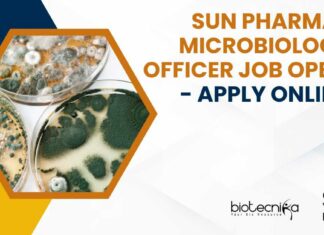
Sun Pharma Microbiology Officer Job Opening – Apply Online Sun Pharma Microbiology Officer
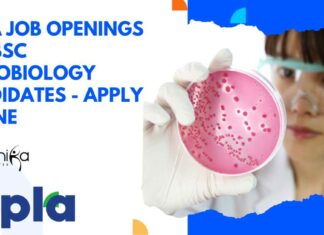
Cipla Job Openings For BSc Microbiology Candidates – Apply Online Cipla Job Openings For BSc Microbiology

FSSAI Food Analyst Exam 2024 Notification – 10th FAE 2024 Eligibility,...
FSSAI Exam 2024 Food Analyst - 10th FAE 2024 Eligibility, Application
FSSAI Exam 2024 Food Analyst - 10th FAE 2024 Eligibility, Application. FSSAI Exam 2024...
Dr Reddy’s QC Job For BS Biology & Microbiology – Apply...
Dr Reddy's QC Job For BS Biology & Microbiology - Apply Online
Team Member Micro Quality Control
Hyderabad, Telangana, India
Dr Reddy’s maintains a work environment free...
Endo Job Opportunity in Microbiology – Apply Online For Analyst Post
Endo Job Opportunity in Microbiology - Apply Online For Analyst Post
Sr Analyst - Microbio
Locations: India - Indore
Time Type: Full time
Posted On: Posted Yesterday
Job Requisition...
Sun Pharma Microbiology Officer Job Opening – Apply Online
Sun Pharma Microbiology Officer Job Opening - Apply Online
Title: Officer - Microbiology
Date: Aug 6, 2024
Location: Mohali - Quality Control
Company: Sun Pharmaceutical Industries Ltd
Responsibility:
Ensure...
CMC Vellore Project Research Scientist Recruitment – Applications Invited
CMC Vellore Project Research Scientist Recruitment - Applications Invited
Department of Clinical Haematology, Christian Medical College
Vellore, Ranipet Campus
Invites application for the post of Project Research...
Transitioning From Wet Lab to Bioinformatics – Complete Guide
Transitioning from Wet Lab to Bioinformatics
Moving from traditional lab work to bioinformatics might seem like entering a completely different world, a world full of...
Cipla Job Openings For BSc Microbiology Candidates – Apply Online
Cipla Job Openings For BSc Microbiology Candidates - Apply Online
Junior Team Member - Microbiology
Posting Date: 22 Jul 2024
Country: India
State: Goa
Location: Goa
Req Id: 86489
Job Purpose
Execute...
UPL Agronomist Recruitment – Apply For Research Assistant – Insecticide
UPL Agronomist Recruitment - Apply For Research Assistant - Insecticide
UPL Agronomist Recruitment - Apply For Research Assistant - Insecticide. Interested and eligible applicants can...
Senior Pharmacovigilance Specialist at Clarivate – Hybrid Work Opportunity
Senior Pharmacovigilance Specialist at Clarivate - Hybrid Work Opportunity
Senior Pharmacovigilance Specialist
Locations: Karnataka, India
Noida, Uttar Pradesh, India
Category: Life Sciences & Healthcare
Remote: Hybrid
Job ID: JREQ128313
Posted Date:...
Freshers Jobs at Biocon Biologics Limited! Apply For QC Microbiologist Analyst...
Freshers Jobs at Biocon Biologics Limited! Apply For QC Microbiologist Analyst Role
Quality Control Microbiologist- Analyst
Location: Bengaluru, Karnataka, India
About the job
About Company
Biocon Biologics Limited, a...
Biotecnika Times Newsletter 06.08.2024 – Govt HSSC Jobs, Freshers WFH Jobs,...
Govt HSSC MSc Biotech, Biochem & Microbiology Scientific Assistant Recruitment - Apply Online
Apply online for the Scientific Assistant positions at HSSC. Open to candidates...
NIBMG Project Research Fellow Recruitment – Applications Invited
NIBMG Project Research Fellow Recruitment - Applications Invited
Advertisement No. NIBMG/ADMIN/ESTB/Proj. Interview/2024-25/171
Date: 02-08-2024
Position Available:
Project Name: MOMI India – Genomics and Analysis Planning (Phase II)
Project Tenure:...
IBAB Bioinformatics, Biology, Biotech, Mol Bio & Life Sciences Project Assistant...
IBAB Bioinformatics Project Assistant Recruitment - Biology, Biotech, Mol Bio & Life Sciences Apply
IBAB
Institute of Bioinformatics and Applied Biotechnology
INSTITUTE OF BIOINFORMATICS AND APPLIED BIOTECHNOLOGY...
Govt HSSC MSc Biotech, Biochem & Microbiology Scientific Assistant Recruitment –...
Govt HSSC Scientific Assistant Recruitment - MSc Biotech, Biochem & Microbiology Apply Online
Advt. No 8/2024
HARYANA STAFF SELECTION COMMISSION
BAYS NO. 67-70, SECTOR-2, PANCHKULA – 134151
Website:...
Exciting Opportunity at National Institute of Immunology: MSc & MTech Life...
MSc Project Jobs at NII Delhi - Applications Invited
NATIONAL INSTITUTE OF IMMUNOLOGY
ARUNA ASAF ALI MARG, NEW DELHI
Applications are invited for the one position of...